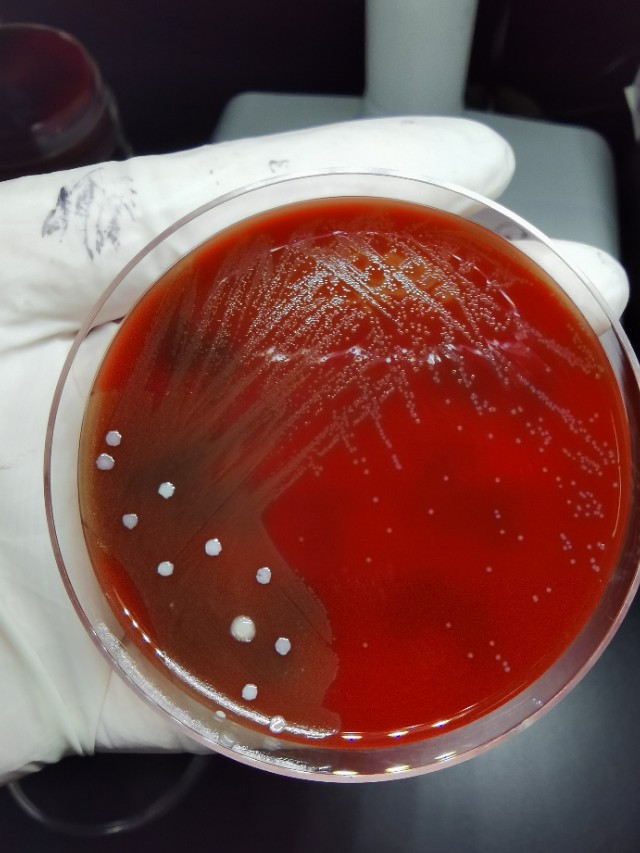
女人有妇科困扰吗,女人常见的妇科问题

从去年九月开始,白带突然增多,黄色,有瘙痒症状!这么多年还是第一次呢!医生都说怀孕期间抵抗力差,容易糟!可我怀了两个孩子都没有糟遇过!后来仔细一想,可能是因为这一年身体暴瘦,身体素质严重下降,抵抗力太差的原因导致的吧!
于是利用职业的便利,自己取了标本做了一个白带常规检查!清洁度三度,偶见真菌孢子,但是有菌丝,确诊真菌性阴道炎!找医生朋友开上的药!效果挺好,两个疗程症状消失!但是有一个后遗症,从此以后白带一直异常,比以往多,还黄,清洁度一直处于三到四度!多次上药都没有啥收效!这个问题一个困扰我至今!
因为疫情,又在新的院区上班,我看病也是拖拖拉拉,大半年!从朋友那里咨询开始,然后找朋友介绍的医生,做了一个阴道镜检查,发现宫颈口并不光滑!同时做了HPV和细胞液基学检查!过了几天,我看到了结果,还好HPV正常,细胞液基学中度炎症!医生建议疫情结束后去妇科做一个小手术取活检!
谁曾想这疫情一直都不结束,我也是拖了好久才去联系的医生梅姐姐取的活检!我把图片给她看,就照着画的位置取了宫颈口的三块肉肉!鉴别一下是癌前病变还是糜烂!当时取活检并不是想象中那么的痛,只是有点不舒服而已!而且还很快,估计也就十来分钟吧!为了防止出血,还压了一块纱布!医生让我第二天才取纱布,同时吃了两天的消炎药!我都不好意思说,第二天我自己取纱布,费了好一会儿功夫才取出来,因为压的比较紧,又比较深!标本送到病理科也就两三天结果就出来了,幸运的是只是慢性宫颈炎伴糜烂!还没有癌变,就没有下一步的锥切!前两天同事刚刚住院去做锥切了!想想也不愉快!做女人的风险太多了!
对于我白带异常的问题,我咨询过好多的医生了!很多不是说继续观察,就是推荐的用药到处买不到!做各种检查找不到具体原因,但我自己就是知道不正常,我也查了很多次白带,和以往比起烦恼多多!这次好姐姐医生燕姐建议我查一个宫颈分泌物培养,对症用药!培养两天后,只培养出了葡萄球菌,没有啥意义!燕姐给我开了一些口服药物,抗菌用的!口服一段时间再说!同时她还推荐我买一个内衣裤消毒烘干机,紫外线都是套路,主要是高温可以消灭大部分的细菌和病毒了!这样比起每次的煮沸也方便许多,比起勤换新的内衣裤更安全了!
继续用药观察吧,希望这次能解决我的烦恼!也得赶快去买个消毒机派上用场,*管双**齐下!
这次吃药三天,发现尿液特别的黄,我开始就看了说明书,这个药同时有治疗泌尿系统感染的作用,担心中又查了一个小便常规,还好正常的!
做女人难,真的好难!三十多年不糟,糟了就甩不脱的感觉!努力提高抵抗力才是王道!
怎样才能提高抵抗力呢?不知道大家是否也有过我这样的遭遇?一起来聊聊吧!#白带异常# #妇科炎症#